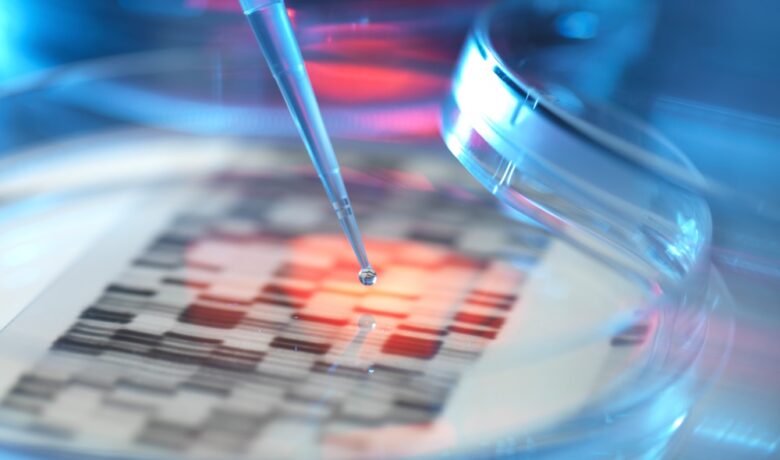

2025年印度吉三代(丙通沙)代购价格公布:约1850元一盒,丙肝患者福音!
关键词:2025印度吉三代、丙通沙、代购价格、丙肝治疗、印度仿制药
2025年,印度吉三代(丙通沙)代购价格正式公布,每盒售价约为1850元至2100元,规格为(400mg+100mg)*28片/瓶。这一消息对于广大丙肝患者来说,无疑是一大福音,意味着更多患者能够以更低的价格获得高效的治疗方案。
吉三代:丙肝治疗领域的革命性突破
吉三代(丙通沙)是由美国吉利德科学公司研发的全球首个全口服、泛基因型、单一片剂的丙肝治疗药物。它通过抑制丙肝病毒复制所需的聚合酶,实现对病毒的有效控制。与传统的干扰素治疗方案相比,吉三代具有治愈率高(99%以上)、疗程短(通常仅需12周)、副作用小等显著优势,成为丙肝治疗领域的革命性突破。
印度吉三代:价格亲民,疗效不打折
由于专利保护,原研药吉三代价格昂贵,给许多患者带来了沉重的经济负担。而印度作为仿制药大国,生产的吉三代在成分、剂量和疗效上与原研药基本一致,但价格却大幅降低。2025年,印度吉三代的代购价格约为1850元至2100元一盒,一个疗程(3个月)的费用仅需5000至6000元,极大减轻了患者的经济压力。
如何购买印度吉三代?两种途径可供选择
目前,国内患者可以通过以下两种途径购买印度吉三代:
- 自行前往印度购买:患者可以亲自前往印度的大型医院药房或授权药店购买。
- 通过专业医疗团队代购:患者可以联系专业的海外医疗服务机构,例如印度安百健海外医疗直邮(微:abn536),他们提供正规的印度吉三代代购服务,支持直邮到家,方便快捷。

国内医保政策:吉三代纳入医保,惠及更多患者
值得一提的是,吉三代(丙通沙)已于近年被纳入我国医保目录,价格由原先的每盒23200元降至约4368元,一个疗程(12周)的费用也仅为13104元。这为国内丙肝患者提供了更多选择,也进一步减轻了患者的经济负担。
结语:
2025年印度吉三代代购价格的公布,为丙肝患者带来了新的希望。无论是选择印度仿制药还是国内医保药物,患者都可以根据自身情况选择最适合的治疗方案。相信随着医疗技术的不断进步和政策的不断完善,未来会有更多丙肝患者能够获得及时、有效的治疗,重获健康!

